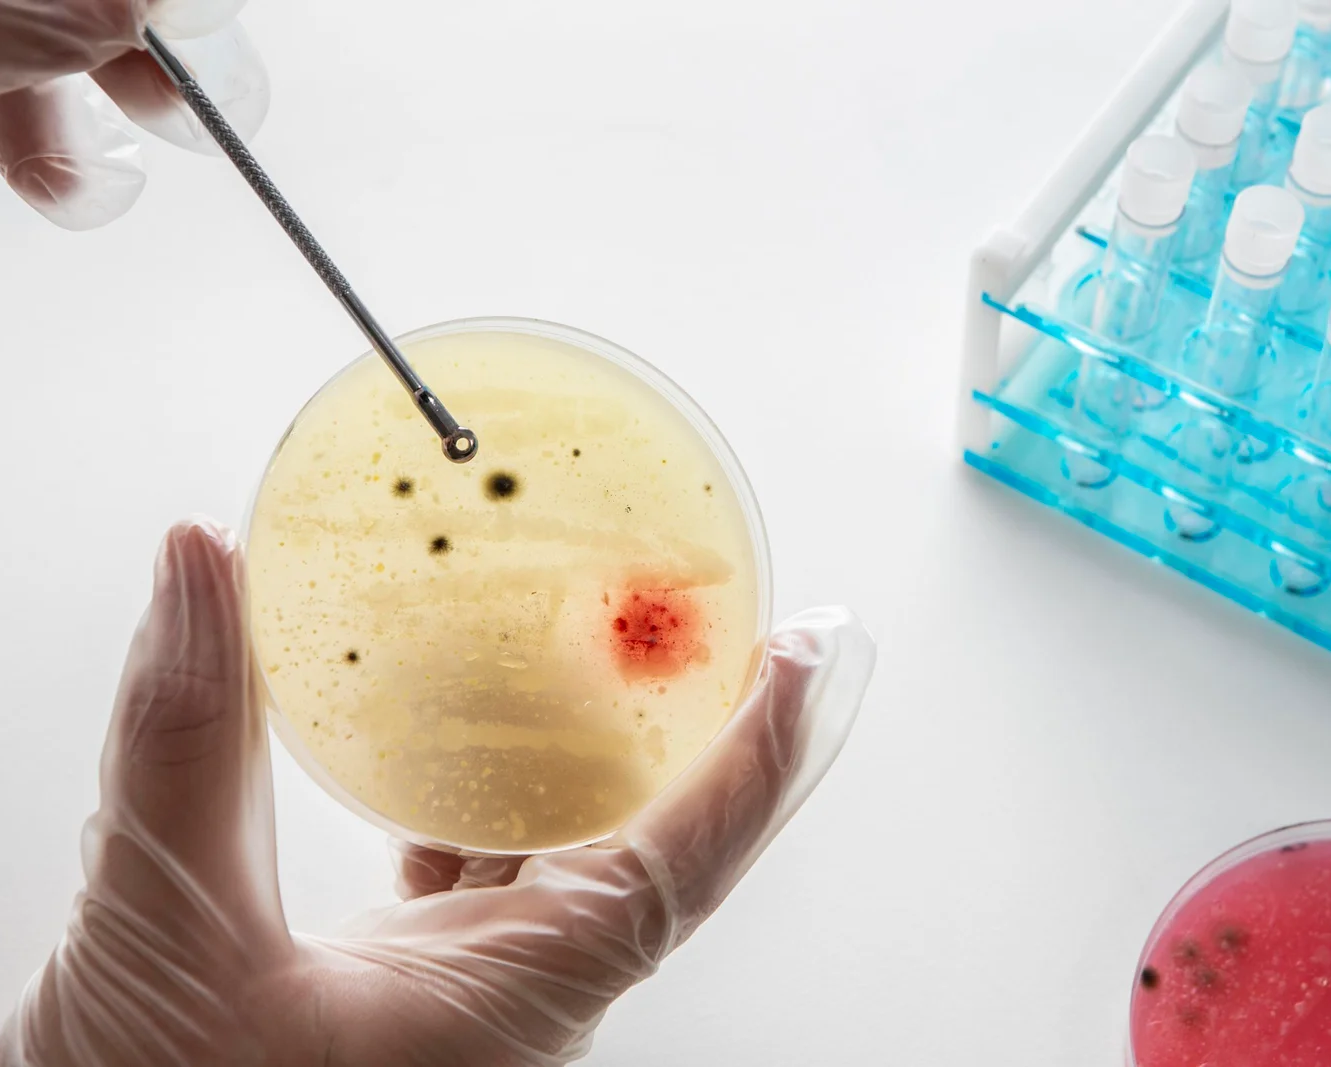
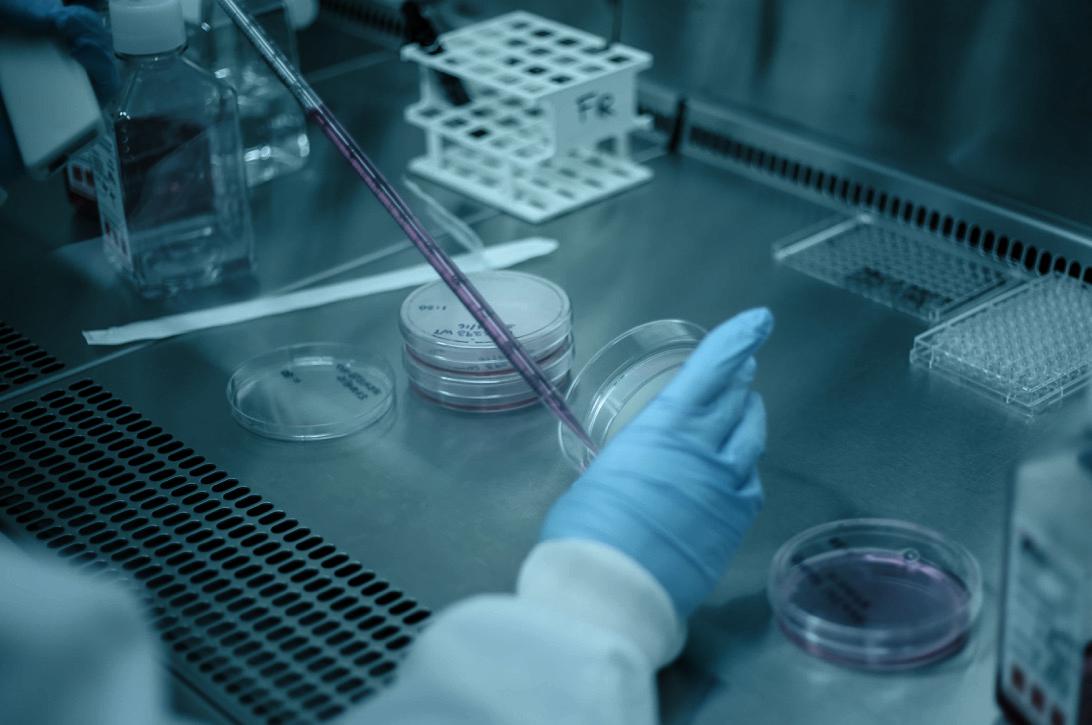

Microbiologie
Laboratoire AL ANOUAR de biologie médicale
Notre service de microbiologie est en charge du diagnostic biologique des agents infectieux dans le sang, les urines, les selles, les expectorations et liquides biologiques. Une discipline qui regroupe la bactériologie, la parasitologie, la mycologie et la virologie. Son activité s’étend du prélèvement des échantillons jusqu’à l’interprétation finale des résultats.